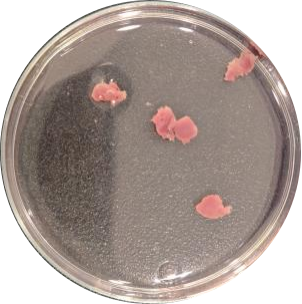
实验秘诀 | 百奥益康心脏解离试剂盒使用攻略及注意事项

实验秘诀 | 百奥益康心脏解离试剂盒使用攻略及注意事项
2025-11-25 09:14点击次数:10
关键词:百奥益康心脏解离试剂盒(货号BA3327)适用于人、小鼠等哺乳动物心脏组织单细胞悬液制备,适配单细胞测序等实验,该文章以预处理、酶解、细胞收集三步核心流程操作,同时搭配对应的注意事项保障实验效果,具体内容如下:

一、使用方法
1. 实验前准备
-
自备仪器与耗材:提前备好水浴锅或杂交炉、水平离心机,以及低吸附枪头、15mL离心管、70μm细胞筛等耗材。
-
自备试剂:准备PBS缓冲液、PBS+5%FBS、RPMI 1640培养基,裂红液等。
-
试剂预处理:将试剂盒从-20℃环境取出,在室温下平衡15 - 30分钟,待试剂完全融化后充分混匀,避免因试剂未融均影响解离效果。
2. 组织解离步骤
-
组织预处理:选取新鲜的心脏组织,先用灭菌后的PBS缓冲液在冰上清洗至少3次,彻底去除血渍和表面杂质;再用无菌剪刀将清洗后的组织剪切成1 - 2mm³的小块,增大组织与解离液的接触面积,为后续酶解做好准备。
-
酶解反应:把剪好的心脏组织小块放入离心管中,加入提前配置好的解离液1中;随后将离心管置于37℃水浴或杂交炉中孵育,过程中可每隔5分钟轻轻颠倒离心管一次,确保组织与解离液充分接触,提升解离效率。解离 20 min 后,加入 300 µL 心脏组织解离液 2,吹打混匀。置于 37℃水浴锅或杂交炉中继续消化5 ~ 10min。根据细胞总量及活性等确定消化停止时间。
-
细胞收集:向离心管中加入1640培养基终止消化反应;接着用70μm细胞筛过滤反应液,收集滤液去除未消化完全的组织碎片;之后将滤液放入水平离心机,以4℃、300×g、离心5min,弃去上清液;清洗两次,最后用适量的PBS+5%FBS重悬细胞,进行质检。
-
后续质控:用细胞计数仪检测细胞悬液的细胞活性和结团率,若悬液中红细胞或细胞碎片过多,可按需进行去除操作,具体可参考红细胞裂解液(货号:BA3311);制备好的单细胞悬液建议尽快用于单细胞测序、细胞培养等后续实验,避免长时间放置导致细胞活性下降。
3. 关键操作技巧
-
组织剪切:确保组织块大小均匀,避免过大(导致解离不充分)或过小(增加细胞损伤),建议在冰上操作以减少细胞代谢损伤。
-
酶解控制:严格控制孵育温度和时间,温度过高或时间过长易导致细胞活性下降;若组织未充分分散,可补加少量酶溶液并延长孵育5-10分钟,但需避免过度酶解。
-
离心参数:离心速度不宜过高(避免细胞破裂),离心后弃上清时需缓慢倾倒,保留少量液体覆盖沉淀,防止细胞丢失。
二、注意事项
1、试剂储存与使用:试剂盒需避免冷冻或反复冻融,未使用的试剂组分需密封后及时放回冰箱,在保质期内使用。酶溶液为关键组分,开启后建议一次性使用,若需分次使用,需分装后-20℃冻存,避免反复冻融超过2次。
2、细胞活性保障:解离过程中尽量缩短样本离体时间,洗涤和离心步骤均在4℃进行,减少细胞暴露于室温的时间。
3、特殊情况调整:若处理的是纤维化程度较高的心脏组织,可适当延长37℃孵育时间,但需密切观察细胞活性,防止过度消化导致细胞活性降低;若组织较嫩,则可按常规20 - 30分钟孵育即可。
4、常见问题处理
-
解离效率低:检查组织块大小是否合适,酶溶液是否失效(如未平衡至室温或反复冻融),可适当延长吹打时间或增加酶浓度。
-
细胞碎片过多:过滤时确保细胞筛孔径匹配(心肌细胞建议用70μm筛网),离心前充分静置使碎片自然沉降,或增加洗涤次数。
-
细胞活性差:排查是否存在酶解过度、离心速度过高或操作时间过长等问题,建议优化步骤并在解离后30分钟内完成后续实验。
三、结果展示
我们对新鲜的小鼠心脏组织进行了实验,结果显示利用心肚组织解离试剂盒解离后获得的细胞悬液质量较好,能满足单细胞转录组测序实验。

通过严格遵循上述攻略和注意事项,可高效获得高活性、高纯度的心脏细胞,保障后续实验结果的可靠性!
百奥益康试剂盒
百奥益康样本保存系列试剂盒:
BA3301,动物组织通用保存液,100 mL,¥1,200
BA3313,胰腺组织保存液,4 rxns,¥2,000
BA3350,动物胃肠道组织保存液,100 mL,¥1,500
BA3312,动物组织冻存液,100 mL,¥2,500
BA3309,通用细胞冻存液,100 mL,¥800
BA3341,无血清无DMSO细胞冻存液,100 mL,¥1,200
百奥益康细胞核悬液制备系列试剂盒:
BA3302,动物组织细胞核悬液制备试剂盒,10 rxns,¥3,000
BA3315,肌肉组织细胞核悬液制备试剂盒,10 rxns,¥3,500
BA3342,脂肪组织细胞核悬液制备试剂盒,10 rxns,¥3,500
BA3343,血管组织细胞核悬液制备试剂盒,10 rxns,¥3,500
BA3319,植物组织通用细胞核悬液制备试剂盒,10 rxns,¥4,000
百奥益康细胞悬液制备系列试剂盒:
BA3303,哺乳动物组织通用解离试剂盒,10 rxns,¥2,500
BA3348,哺乳动物组织通用解离试剂盒(Plus版),10 rxns,¥3,000
BA3344,通用外周血单个核细胞(PBMC)分离液(沉降法),100 mL,¥300
BA3331,小鼠外周血单个核细胞(PBMC)分离液,100 mL,¥500
BA3332,人外周血单个核细胞(PBMC)分离液,100 mL,¥500
BA3333,人骨髓血单个核细胞(BMMC)分离液,100 mL,¥500
BA3305,小鼠脑组织解离试剂盒,10 rxns,¥3,000
BA3326,人脑组织解离试剂盒,10 rxns,¥3,000
BA3307,皮肤组织解离试剂盒,10 rxns,¥2,000
BA3340,小鼠皮肤组织解离试剂盒,10 rxns,¥2,000
BA3308,骨组织解离试剂盒,10 rxns,¥4,000
BA3310,血管组织解离试剂盒,10 rxns,¥9,000
BA3337,血管组织解离试剂盒(Plus),10 rxns,¥12,000
BA3314,胰腺组织解离试剂盒,4 rxns,¥6,000
BA3320,肿瘤组织解离试剂盒,10 rxns,¥2,000
BA3349,肿瘤组织解离试剂盒(Plus版),10 rxns,¥3,000
BA3321,耳蜗组织解离试剂盒,10 rxns,¥4,000
BA3322,肾脏组织解离试剂盒,10 rxns,¥2,500
BA3323,肝脏组织解离试剂盒,10 rxns,¥2,500
BA3324,脾脏组织解离试剂盒,10 rxns,¥2,000
BA3325,肺脏组织解离试剂盒,10 rxns,¥2,000
BA3327,心脏组织解离试剂盒,10 rxns,¥5,000
BA3328,气管组织解离试剂盒,10 rxns,¥4,000
BA3316,胃肠道组织解离试剂盒,10 rxns,¥5,000
BA3334,脊髓组织解离试剂盒,10 rxns,¥4,000
BA3336,输卵管组织解离试剂盒,10 rxns,¥5,000
BA3335,环节动物组织解离试剂盒,10 rxns,¥6,000
BA3347,蛾肠道组织解离试剂盒,10 rxns,¥2,500
BA3351,卵巢组织解离试剂盒,10 rxns,¥2,500
BA3352,小型哺乳动物卵巢组织解离试剂盒,10 rxns,¥2,500
BA3317,植物组织通用原生质体悬液制备试剂盒,10 rxns,¥6,000
百奥益康细胞悬液优化系列试剂盒:
BA3311,红细胞裂解液,100 mL,¥150
BA3345,抗细胞结团剂,100 mL,¥1,500
BA3338,死细胞去除缓冲液,10 rxns,¥2,000
BA3339,死细胞碎片杂质去除试剂盒,10 rxns,¥4,000
BA3329,消化系统组织细胞碎片去除试剂盒,10 rxns,¥4,000
BA3330,脑组织细胞碎片去除试剂盒,10 rxns,¥2,000



